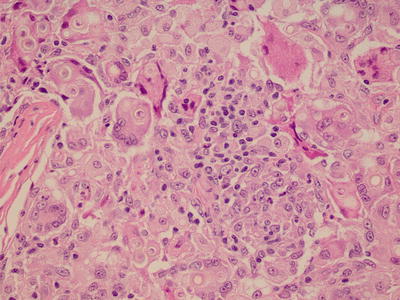
A338357_1_En_4_Fig21_HTML.jpg

, Jane Tomimori1, Sofia Beatriz Machado de Mendonça1 and Douglas Antonio Rodrigues1
(1)
Universidade Federal de São Paulo, São Paulo, Brazil
4.1 Fungal Diseases
4.1.1 Dermatophytosis
Fungal diseases are diseases that affect the skin and appendages (hair and nails). They are caused by fungi known as dermatophytes, which may be anthropophilic, zoophilic, or geophilic. One of the characteristics of these fungi is their affinity for keratin present on the skin, hair, and nails.
These frequent diseases are common in children and adults. Transmission can occur through personal contact, contact with animals (dogs, cats), and contact with the ground.
The most frequent causative agent is Trichophyton rubrum , which causes lesions on the nails, feet, and groin. Older people are most affected. Microsporum canis is another frequent etiological agent. It infects animals like cats (which can be only carriers) or dogs (which in general experience hair loss).
The infection can affects any site in the body, including hair and nails. Dermatophytoses go by different names based on the area of the body affected: tinea corporis, tinea pedis, tinea capitis, tinea inguinalis, and onycomychosis.
Tinea corporis presents with itchy lesions as well as erythematous and scaly well-defined borders. These lesions might have an annular shape and may be single or multiple (Figs. 4.1 and 4.2) . Tinea pedis is common in individuals who use closed shoes and has been related to increased foot sweating. Lesions may affect the interdigital region (Fig. 4.3) . Bromidrosis, itching, and local maceration are part of the clinical presentation. Dry desquamation of the foot occurs in the chronic form. Tinea capitis presents as hair loss (alopecia) and squamous skin in these areas. It is common in children. Tinea inguinalis is more common in men, occurs in the warmer months, and has been related to the use of clothes and local sweating. The lesions are erythematous and scaly, and there is intense itching. In onychomycosis, there is a detachment of the nail that evolves with thickening of the nail plate. Nail dyschromia (yellowish or blackened nails) is also common (Fig. 4.4) . There is a form of mycosis in which the fungus is located deeply in the skin, causing folliculitis and perifolliculitis. It is called granuloma trichophyticum . Clinically the lesions are erythematous papules or papule pustules and mainly affect the extremities or face.





Fig. 4.1
Tinea corporis : lesion on leg

Fig. 4.2
Tinea corporis : lesion on armpit

Fig. 4.3
Tinea pedis : lesions on interdigital region

Fig. 4.4
Onichomycosis : nail dystrophy
For diagnostic confirmation a direct mycological examination is performed. By scraping the edge of the lesions with a blade skin scales are obtained that are placed on a glass slide. After adding a drop of solution of KOH (potassium hydroxide) at 10%, a reading can be obtained in an optical microscope (Figs. 4.5 and 4.6) . The fungus culture in the appropriate medium determines the species of fungus.



Fig. 4.5
Dermatophytosis: direct mycological examination of scales (40×) (Photo by Orion Sant Ana Motter Borba)

Fig. 4.6
Dermatophytosis: direct mycological examination of hair (40×) (Photo by Orion Sant Ana Motter Borba)
The treatment will be selected according to the extent of the disease, its location, the patient’s clinical condition, and the causative agent. As a rule, treatment with topical medications is sufficient (clotrimazole, miconazole, terbinafine, amorolfine, ketoconazole, and others). The use of systemic antifungals (fluconazole, itraconazole, griseofulvin, terbinafine) is indicated in cases of extensive lesions in the skin.
4.1.2 Paronychia
Paronychia is a common disease affecting mainly adults whose hands are continually exposed to moisture (water). Candida spp. Fungi are involved in the pathogenesis. Association with Staphylococcus spp. is common. The clinical presentation is a swelling of the proximal nail region associated with erythema. When chronic, the area is hardened (Figs. 4.7 and 4.8) and the nail becomes irregular, yellow, and thickened. If there is secondary bacterial infection, the region becomes swollen again, in addition to experiencing local pain and purulent discharge. For diagnosis confirmation, a direct mycological examination involving skin scraping (scales) can be carried out. However, a secondary bacterial infection is accompanied by a lower direct mycological positivity.



Fig. 4.7
Paronychia: lesions on proximal nail region

Fig. 4.8
Paronychia: lesions on proximal nail region
Usually treatment with topical medications is sufficient. Nystatin or azoles (ketoconazole, miconazole, clotrimazole) should be applied twice daily until clinical cure occurs. In case of a secondary bacterial infection, topical antibiotics (gentamicin, neomycin, mupirocin, or fusidic acid cream) should be used. In some cases a combination of topical corticosteroids with topical antibiotics may be used (betamethasone/gentamicin, betamethasone/fusidic acid). In rare cases, systemic drugs are necessary.
4.1.3 Pityriasis Versicolor
Pityriasis versicolor is a superficial fungal infection caused by Malassezia spp. Fungi. It is a common disease that affects adults and, rarely, children before puberty. However, it is not highly transmissible like other superficial mycoses. It occurs more often in tropical and subtropical regions during hot and humid months. Lesions become more apparent after sunlight exposure due to a color contrast because the parasitized site does not tan. The clinical presentation is white, erythematous, or brownish macules, usually round and with fine scaling. The macules usually occur on the back, chest, neck, face, and arms (Figs. 4.9, 4.10, and 4.11) and are asymptomatic .




Fig. 4.9
Pityriasis versicolor: lesions on dorsum

Fig. 4.10
Pityriasis versicolor: lesions on dorsum

Fig. 4.11
Pityriasis versicolor: lesions on face
When necessary, a direct microscopic examination by skin scraping (scales) can confirm the diagnosis (Fig. 4.12) . Fungal culture or molecular biology tests can identify the fungal species. Treatment with topical medications (clotrimazole, miconazole, terbinafine, amorolfine, ketoconazole, and others) is sufficient in most cases. Shampoos (ketoconazole, ciclopirox olamine, zinc pyrithione, selenium sulfide) are effective too. If the affected area of the skin is large, systemic drugs are indicated (fluconazole in weekly doses or itraconazole).


Fig. 4.12
Pityriasis versicolor: direct mycological examination of scales (40×) (Photo by Orion Sant Ana Motter Borba)
4.1.4 Tinea Imbricata
Tinea imbricata is a rare fungal infection caused by Trichophyton concentricum .
It occurs in tropical areas and has been associated with the Xingu Indigenous Park (Brazil). In some indigenous languages it is known as tokelau or chimberê . The main characteristic is the presence of scaly lesions in a concentric arrangement (in regular circles), located on the trunk, arms, and legs, that can affect a large area of the skin (Figs. 4.13 and 4.14). Direct microscopic examination by skin scraping (scales) can be used to confirm the fungus’s presence. However, the fungal species can be determined with certainty only in culture. Treatment is carried out with the same topical medications that are used to treat dermatophytoses (clotrimazole, miconazole, terbinafine, amorolfine, ketoconazole, and others). The use of systemic antifungals (fluconazole, itraconazole) is indicated when a large area of skin is affected .



Fig. 4.13
Tinea imbricate: disseminated lesions

Fig. 4.14
Tinea imbricate: disseminated lesions
4.1.5 Jorge Lobo’s Disease
Jorge Lobo’s disease affects the skin and subcutaneous tissue and is caused by the fungus Lacazia loboi . The Caiabi Indians call it miraip. Only a few hundred cases have been reported in the world. It is found mainly in the Amazon region in individuals who frequent the forests (e.g., hunters). There is a large number of cases among the Caiabi Indians. The path of transmission is not known. However, among the Kayapo, it is believed that the disease was acquired in its original territory 300 km to the north of the Xingu Indigenous Park (XIP) . Many Caiabi Indians have migrated to the XIP in the last 40 years, and no new cases of Jorge Lobo’s disease native to XIP has emerged. We know that the disease is probably not transmitted from person to person. In addition to humans, the disease also affects some species of cetaceans (Tursiops truncatus and Sotalia guianensis).
The clinical presentation of Jorge Lobo’s disease is polymorphic. Many types of skin lesions are observed: reddish color and hardened nodules or plaques, atrophic lesions, and keloid-like lesions. The lesions can affect any body region and may be single or multiple (Figs. 4.15, 4.16, 4.17, 4.18, and 4.19) . Ulcers can be observed in nodules as in atrophic lesions (Fig. 4.20) . The overall health of the patient is not affected unless there are complications such as bacterial infections. The transformation into squamous-cell carcinoma is unusual, but it can occur.







Fig. 4.15
Jorge Lobo’s disease: multiple lesions

Fig. 4.16
Jorge Lobo’s disease: single lesion

Fig. 4.17
Jorge Lobo’s disease: multiple lesions

Fig. 4.18
Jorge Lobo’s disease: destructive lesions

Fig. 4.19
Jorge Lobo’s disease: multiple lesions

Fig. 4.20
Jorge Lobo’s disease: ulcers lesions
Diagnosis is made by direct microscopic examination. A pathological examination will show the presence of lymphocytic infiltrate and round fungal structures with birefringent walls, isolated or grouped in the form of chains (Figs. 4.21 and 4.22) . To date, no one can grow the Lacazia loboi fungus in culture medium. There is an antigenic resemblance between the fungi Lacazia loboi and Paracoccidioides braziliensis .

Fig. 4.21
Jorge Lobo’s disease: skin biopsy, hematoxylin–eosin staining

Fig. 4.22
Jorge Lobo’s disease: skin biopsy, silver-methenamine staining
Treatment is difficult because there are no known effective drugs against the disease. There are reports of the use of systemic drugs like ketoconazole, itraconazole, posaconazole, clofazimine, amphotericin B, and 5-fluorocytosine, as well as a multidrug therapy for multibacillary leprosy with little in the way of results. In some cases the surgical removal of lesions may heal the patient, especially if it done early (at the initial stage and when there are few lesions).
4.1.6 Chromoblastomycosis
These mycoses, which are caused by a group of dark fungi, affect the skin and subcutaneous tissue . The most common etiological agents change depending on the geographic region. The most common agent in Brazil is Fonsecaea pedrosoi . These diseases occur in tropical countries, especially in rural areas. The infection occurs by a trauma to the skin where the fungus penetrates; thus, it is a mycosis of implantation. Local fungus development will occur depending on the immune status of the host.
The emergence of papules or nodules that develop into a large verrucous plaque is the primary clinical manifestation (Figs. 4.23 and 4.24) . The presence of black dots on the lesions is characteristic of this infection (Fig. 4.25) . Usually the injury is unilateral, preferentially in the lower limbs (foot or leg). A bacterial infection can occur over the lesion, and there is a nasty odor. Evolution into squamous-cell carcinoma can occur.




Fig. 4.23
Chromoblastomycosis: verrucous plaque

Fig. 4.24
Chromoblastomycosis: verrucous plaque

Fig. 4.25
Chromoblastomycosis: verrucous plaque with black dots
Direct mycological examination of skin scales may show typical fungal structures in an optical microscope (Fig. 4.26) . These skin scales should come from the areas around the black dots of the skin lesions. Fungal culture will define the species of the etiological agent. Histopathological examination of a skin biopsy is characteristic but does not define the species of the causative agent.


Fig. 4.26
Chromoblastomycosis: direct mycological examination of scales (100×)
Treatment is difficult, especially in advanced stages. If lesions are small, surgery can be curative. Systemic antifungals (itraconazole, ketoconazole, fluconazole, terbinafine, 5-flucytosine) can be associated with surgical treatments (e.g., excision of lesions, cryosurgical with liquid nitrogen, electrocoagulation).
4.1.7 Mycetoma
Mycetomas are a group of infectious diseases that affect the skin and subcutaneous tissue. They can be caused by various bacterial species (endogenous and exogenous actinomycetomas) and fungi (eumycetoma). They share common clinical and histopathological characteristics , even if caused by different etiological agents.
Exogenous actinomycetoma and eumycetoma are more common in warm climates (tropical, subtropical, and desert areas) and are associated to people who have contact with soil and plants (rural). The disease generally affects the extremities, especially the feet. Endogenous actinomycetoma lacks this epidemiological link. Therefore, it may be found anywhere in the world and may occur following surgery.
There are clinical and pathological similarities among the mycetomas despite the different etiological agents. Exogenous actinomycosis and mycetoma are characterized by hardened tumor lesions, microabscesses, and fistulas, in addition to secretions. In such secretions, granules and grains may be present. The lesions are usually unilateral and the lower limbs are the preferential locations (Fig. 4.27). These areas are more subject to trauma. The trauma is the likely form of inoculation of the causative agent. There is usually no pain or systemic symptoms.


Fig. 4.27
Mycetoma: tumor lesion with fistulae
Exogenous actinomycosis is caused by aerobic bacteria of different species (e.g., Nocardia brasiliensis), while the eumycetoma is caused by several species of fungi (e.g., Madurella mycetomatis). Endogenous actinomycosis is characterized by fistula-draining secretions with beads or grains, which are located in the neck, face, thorax, or abdomen. They are caused by anaerobic bacteria localized in the oral cavity, lungs, and intestines. Endogenous actinomycosis is a systemic disease on which more research is needed in other body organs.
Diagnosis is confirmed by direct examination of removed secretion through cutaneous fistulae (with the addition of 10% potassium hydroxide solution, the grains can be visualized in this material ; see Figs. 4.28 and 4.29).



Fig. 4.28
Actinomycetoma : direct mycological examination of secretion (100×) (Photo by Orion Sant Ana Motter Borba)

Fig. 4.29
Eumycetoma : direct mycological examination of secretion (100×) (Photo by Orion Sant Ana Motter Borba)
Histopathological examination or cultures for fungi and aerobic and anaerobic bacteria can be performed. The diagnosis of mycetoma cannot be excluded if the characteristic grains are not evidenced in the histopathological examination since often they are deep in the lesions, requiring a deep exploration of the fistulae to find them.
Drug therapy will be conducted based on the etiological agent:
- (a)
Endogenous actinomycosis : systemic antibiotic therapy (G-crystalline penicillin, ampicillin, tetracycline, or erythromycin);
- (b)
Exogenous actinomycosis : systemic antibiotic therapy (diamino-diphenyl sulfone, sulfamethoxazole-trimethoprim, rifampicin, aminoglycosides, quinolones, amoxicillin, tetracyclines or carbepenens);
- (c)
Eumycetoma : systemic antifungals (ketoconazole, itraconazole, terbinafine, potassium iodide, amphotericin-B, voriconazole or posaconazole) .
Surgical procedures may be necessary depending on each clinical situation. For instance, if lesions are beginning and small, their complete excision can control or cure the disease.
4.2 Bacterial Diseases
4.2.1 Impetigo
Impetigo is a skin disease caused by bacteria, mainly Staphylococcus aureus and Streptococcus pyogenes . It is a common and very contagious disease that is more prevalent in children. This superficial infection may result from contamination of any preexisting injury or through the action of scratching.
In some indigenous areas, during the dry season there is a great proliferation of mosquitoes . The itching caused by the bite of these insects can evolve into abrasions that become a gateway to bacteria, often resulting in impetigo.
The disease is characterized by pustules and blisters with purulent contents and erythema at the base of the lesion. Pus and crusts may develop anywhere on the skin, but they are more common on the face and upper and lower limbs (Figs. 4.30, 4.31, 4.32, and 4.33) . If not treated properly it can progress to deeper infections like erysipela.





Fig. 4.30
Impetigo: skin lesions on dorsum

Fig. 4.31
Impetigo: skin lesions on face and ear

Fig. 4.32
Impetigo: skin lesions on leg

Fig. 4.33
Impetigo: skin lesions on ear
In most cases diagnosis is made by clinical observations. If necessary, the material (pus or secretion) is collected for bacterioscopic tests and culture for bacteria . The ideal is to collect the material from a pustule. After local cleansing, break the pustule with a small sterile needle and collect the pus with a sterile swab.
Treatment consists in cleaning the lesions with water and soap or with saline solution. Topical antibiotics can be used if few cutaneous lesions (neomycin, gentamicin, 2% mupirocin, 2% fusidic acid, or 1% retapamulin, bid). If there are many lesions or if fever or other symptoms are present, use systemic antibiotics (penicillins, cephalosporins, macrolides).
4.2.2 Bacterial Folliculitis
Bacterial folliculitis is a skin infection caused by Staphylococcus aureus . It is related to hair follicles and can be superficial or deep. It can occur at any age. The deeper forms occur in adults. Bacterial folliculitis does not appear to be more frequent in indigenous compared to Caucasian or African populations.
The superficial form is also known as ostiofollulitis or impetigo of Bockhart and presents as a pustule in the hair follicles. When breaking, it evolves with the formation of crust. It does not destroy hair follicles. It is a form of impetigo of follicular localization (Fig. 4.34).


Fig. 4.34
Bacterial folliculitis: skin lesions on thigh
The deep form, called sycosis barbae , is characterized by follicular pustules that can progress to a chronic state if not properly treated. It should be differentiated from trichophytic sycosis (caused by fungi). Mycological and bacterioscopic examinations are necessary for differentiation, since their clinical pictures may be indistinguishable.
Another deep form, the hordeolum, affects the eyelashes (meibomian glands) with the formation of pustules or painful erythematous nodules. Pruritic lesions on the eyelid, seborrheic dermatitis on the eyelashes, and refractive defects may be predisposing factors. Fungi or bacteria cultures are indicated when there is doubt about the etiological agent. Antibiotic therapy can be used if fungal etiology is ruled out. The treatment is similar to impetigo and consists in cleaning the lesions with water and soap or with saline solution. In extensive lesions, systemic antibiotics are used (penicillins, cephalosporins, macrolides) .
4.2.3 Erysipelas and Cellulitis
Erysipelas and cellulitis are skin and subcutaneous tissue diseases caused by bacteria, mainly beta-hemolytic streptococci. They are common diseases and can occur at any age. They can arise from complications related to other skin diseases such as bacterial diseases (e.g., impetigo), fungal diseases (such as of the foot), or skin ulcers (traumatic or varicose ulcers). Fever, chills, and a bad general condition are frequent symptoms in afflicted patients.
The affected area of the skin becomes reddish (erythematous), edematous, hot, and painful (Fig. 4.35). Blisters with purulent contents can occur, representing a sign of disease severity (Staphylococcus aureus infection ). Face and lower limbs are generally more affected, but any area of the body can be involved. Cellulitis occurs when the infectious condition is deeper. If it occurs on the face, it is quite serious. In patients with diabetes mellitus, obesity, or varicose veins in the legs, erysipelas and cellulits are more common.






